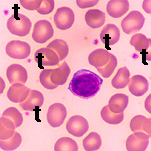

Trombociti su krvne pločice tj. malena, bezbojna tjelašca bez jedra. U litri krvi ih ima od 150 – 400 ·109. Nastaju u koštanoj srži iz dijelova megakariocita (stanice s velikim jedrom). Vrlo brzo se raspadaju, te im život traje relativno kratko – od 3 do 5 dana. Veličina je mala, 2-4 mikrona. U građi razlikujemo periferni i centralni dio. Periferni dio je citoplazma i zove se hijalomera, a centralni dio se sastoji iz zrnaca i zove se hromomera. Hemijski sastav najveći dio čini voda 86-88%, a ostatak su organske i neorganske tvari. Bjelančevina ima najviše oko 57%, a lipida oko 19%.


Fizičke osobine su: adhezivnost, agregacija, aglutinacija i viskozna metamorfoza. Adhezivnost je sposobnost lakog priljubljivanja za svaku površinu koja se vlaži, agregacija je sposobnost sljepljivanja trombocita u gomilice koje se mogu rastaviti, aglutinacija je sposobnost trajnog sljepljivanja u gomilice, viskozna metarmorfoza je mijenjanje građe aglutinisanih trombocita, pri čemu grupice bubre i pojedinačni trombociti se ne raspoznaju. Veoma važnu ulogu u procesu zgrušavanja krvi jer je održavanje krvi u tekućem stanju unutar krvotoka i zaustavljanje krvarenja pri oštećenju krvnih žila (hemostaza) važan mehanizam za očuvanje stalnih uslova u kojima funkcioniše organizam.
![]() |
![]() |
![]() |
![]() |
![]() |
![]() |